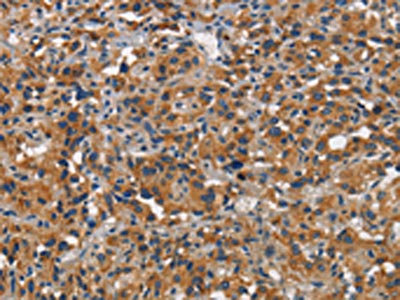

CEACAM1 Antibody
-
中文名稱:CEACAM1兔多克隆抗體
-
貨號(hào):CSB-PA939516
-
規(guī)格:¥1100
-
圖片:
-
The image on the left is immunohistochemistry of paraffin-embedded Human liver cancer tissue using CSB-PA939516(CEACAM1 Antibody) at dilution 1/30, on the right is treated with synthetic peptide. (Original magnification: ×200)
-
The image on the left is immunohistochemistry of paraffin-embedded Human thyroid cancer tissue using CSB-PA939516(CEACAM1 Antibody) at dilution 1/30, on the right is treated with synthetic peptide. (Original magnification: ×200)
-
Gel: 6%SDS-PAGE, Lysate: 40 μg, Lane: Human metastatic malignant melanoma tissue, Primary antibody: CSB-PA939516(CEACAM1 Antibody) at dilution 1/300, Secondary antibody: Goat anti rabbit IgG at 1/8000 dilution, Exposure time: 20 seconds
-
-
其他:
產(chǎn)品詳情
-
Uniprot No.:
-
基因名:
-
別名:Antigen CD66 antibody; BGP 1 antibody; BGP antibody; BGP-1 antibody; BGPI antibody; Biliary glycoprotein 1 antibody; Biliary glycoprotein adhesion molecule antibody; Biliary glycoprotein antibody; Carcinoembryonic antigen related cell adhesion molecule 1 antibody; carcinoembryonic antigen-related cell adhesion molecule 1 (biliary glycoprotein) antibody; Carcinoembryonic antigen-related cell adhesion molecule 1 antibody; CD66a antibody; CD66a antigen antibody; CEACAM1 antibody; CEAM1_HUMAN antibody; meconium antigen 100 antibody
-
宿主:Rabbit
-
反應(yīng)種屬:Human
-
免疫原:Synthetic peptide of Human CEACAM1
-
免疫原種屬:Homo sapiens (Human)
-
標(biāo)記方式:Non-conjugated
-
抗體亞型:IgG
-
純化方式:Antigen affinity purification
-
濃度:It differs from different batches. Please contact us to confirm it.
-
保存緩沖液:-20°C, pH7.4 PBS, 0.05% NaN3, 40% Glycerol
-
產(chǎn)品提供形式:Liquid
-
應(yīng)用范圍:ELISA,WB,IHC
-
推薦稀釋比:
Application Recommended Dilution ELISA 1:2000-1:5000 WB 1:500-1:2000 IHC 1:25-1:100 -
Protocols:
-
儲(chǔ)存條件:Upon receipt, store at -20°C or -80°C. Avoid repeated freeze.
-
貨期:Basically, we can dispatch the products out in 1-3 working days after receiving your orders. Delivery time maybe differs from different purchasing way or location, please kindly consult your local distributors for specific delivery time.
-
用途:For Research Use Only. Not for use in diagnostic or therapeutic procedures.
相關(guān)產(chǎn)品
靶點(diǎn)詳情
-
功能:Cell adhesion protein that mediates homophilic cell adhesion in a calcium-independent manner. Plays a role as coinhibitory receptor in immune response, insulin action and functions also as an activator during angiogenesis. Its coinhibitory receptor function is phosphorylation- and PTPN6 -dependent, which in turn, suppress signal transduction of associated receptors by dephosphorylation of their downstream effectors. Plays a role in immune response, of T cells, natural killer (NK) and neutrophils. Upon TCR/CD3 complex stimulation, inhibits TCR-mediated cytotoxicity by blocking granule exocytosis by mediating homophilic binding to adjacent cells, allowing interaction with and phosphorylation by LCK and interaction with the TCR/CD3 complex which recruits PTPN6 resulting in dephosphorylation of CD247 and ZAP70. Also inhibits T cell proliferation and cytokine production through inhibition of JNK cascade and plays a crucial role in regulating autoimmunity and anti-tumor immunity by inhibiting T cell through its interaction with HAVCR2. Upon natural killer (NK) cells activation, inhibit KLRK1-mediated cytolysis of CEACAM1-bearing tumor cells by trans-homophilic interactions with CEACAM1 on the target cell and lead to cis-interaction between CEACAM1 and KLRK1, allowing PTPN6 recruitment and then VAV1 dephosphorylation. Upon neutrophils activation negatively regulates IL1B production by recruiting PTPN6 to a SYK-TLR4-CEACAM1 complex, that dephosphorylates SYK, reducing the production of reactive oxygen species (ROS) and lysosome disruption, which in turn, reduces the activity of the inflammasome. Downregulates neutrophil production by acting as a coinhibitory receptor for CSF3R by downregulating the CSF3R-STAT3 pathway through recruitment of PTPN6 that dephosphorylates CSF3R. Also regulates insulin action by promoting INS clearance and regulating lipogenesis in liver through regulating insulin signaling. Upon INS stimulation, undergoes phosphorylation by INSR leading to INS clearance by increasing receptor-mediated insulin endocytosis. This inernalization promotes interaction with FASN leading to receptor-mediated insulin degradation and to reduction of FASN activity leading to negative regulation of fatty acid synthesis. INSR-mediated phosphorylation also provokes a down-regulation of cell proliferation through SHC1 interaction resulting in decrease coupling of SHC1 to the MAPK3/ERK1-MAPK1/ERK2 and phosphatidylinositol 3-kinase pathways. Functions as activator in angiogenesis by promoting blood vessel remodeling through endothelial cell differentiation and migration and in arteriogenesis by increasing the number of collateral arteries and collateral vessel calibers after ischemia. Also regulates vascular permeability through the VEGFR2 signaling pathway resulting in control of nitric oxide production. Downregulates cell growth in response to EGF through its interaction with SHC1 that mediates interaction with EGFR resulting in decrease coupling of SHC1 to the MAPK3/ERK1-MAPK1/ERK2 pathway. Negatively regulates platelet aggregation by decreasing platelet adhesion on type I collagen through the GPVI-FcRgamma complex. Inhibits cell migration and cell scattering through interaction with FLNA; interfers with the interaction of FLNA with RALA. Mediates bile acid transport activity in a phosphorylation dependent manner. Negatively regulates osteoclastogenesis.; Cell adhesion protein that mediates homophilic cell adhesion in a calcium-independent manner. Promotes populations of T cells regulating IgA production and secretion associated with control of the commensal microbiota and resistance to enteropathogens.
-
基因功能參考文獻(xiàn):
- regulator of local immune response in the liver, whereby CEACAM1S seems to control regulatory T cell induction PMID: 29377208
- These experiments also confirmed that protein levels of CEACAM-1, which functions in cell adhesion, is dependent on LLO biosynthesis in vivo. Kato III cells and the MPDU1-rescued Kato IIIM cells therefore provide a novel model to examine the consequences of defective LLO biosynthesis both in vitro and in vivo. PMID: 29671116
- The MAPK-driven CEACAM1p activity is mediated by ETS1. PMID: 29558679
- CEACAM1 mRNA or protein expression are independent prognostic markers for ovarian cancer carcinomas. PMID: 30050594
- We suggest that CEACAM1 could be a prognostic marker of oral squamous cell carcinoma and oral carcinoma in situ. Our most important finding was that it could help pathologists diagnosing oral carcinoma in situ PMID: 28887602
- GNAS mutation is a highly specific test for IPMN. When GNAS testing is added to CEA and KRAS, a significantly greater overall accuracy (86.2%) is achieved. PMID: 27514845
- CEACAM1 single nucleotide polymorphisms association with lymphedema caused by Wuchereria bancrofti. PMID: 29122006
- HBx, VEGF and CEACAM1 were widely expressed in HBV-related HCC. HBx may facilitate occurrence and progression of HBV-related HCC via down-regulating CEACAM1 and up-regulating VEGF. PMID: 28975984
- these data identify CEACAM1 as a clinically highly interesting target in multiple sclerosis pathogenesis and open new therapeutic avenues for the treatment of the disease. PMID: 27435215
- serum levels of CEACAM1 in healthy pregnant women were much lower than in non-pregnant women PMID: 28593707
- CEACAM1 overexpression significantly suppressed MM cell proliferation, induced cell apoptosis, and inhibited cell invasion and migration possibly through activation of caspase-3 and downregulation of MMP-2 and MMP-9. PMID: 29486474
- Data suggest that the serum level of carcinoembryonic antigen-related cell adhesion molecule 1 (CEACAM1) may be used to discriminate gastrointestinal cancer patients from health controls. PMID: 28655144
- In this paper, a dual-target electrochemical aptasensor has been developed for simultaneous detection of carcinoembryonic antigen and mucin-1 based on metal ion electrochemical labels and Ru(NH3)6(3+) electronic wires PMID: 28732346
- Furthermore, the proposed aptasensor was successfully applied in determining CEA in serum samples, showing its superior prospects in clinical diagnosis. PMID: 28735043
- we show here that Human Metapneumovirus (HMPV)-infected cells upregulates CEACAM1 to restrict HMPV infection PMID: 27634893
- Helicobacter pylori HopQ binds the amino-terminal IgV-like domain of human CEACAM1, CEACAM3, CEACAM5 or CEACAM6 proteins, thereby enabling translocation of the major pathogenicity factor CagA into host cells. PMID: 27748756
- Here, the authors identify members of the carcinoembryonic antigen-related cell adhesion molecule (CEACAM) family as receptors of Helicobacter pylori and show that HopQ is the surface-exposed adhesin that specifically binds human CEACAM1, CEACAM3, CEACAM5 and CEACAM6. PMID: 27748768
- Data show that SOX9 regulates CEACAM1 primarily via Sp1 and ETS1. PMID: 26885752
- short cytoplasmic domain isoforms at the primary lesion invasion front associated with recurrence and prognosis of patients with colorectal liver metastasis after curative hepatectomy; expression of CEACAM1-4S enhances the tumor-initiating property of colorectal cancer cells PMID: 29180203
- Results report that CEACAM1 was uniquely expressed at high levels in both human neoplastic mast cells (mastocytosis) and medullary thyroid carcinoma cell (MTC) lines, and suggest that the dominantly interacting proteins SHP1 or SFK determine whether CEACAM1-L displays a positive or negative role in tumor cells. . PMID: 28332308
- SASH1 acts through NOTCH1 and its inhibitor DLK1 in a three-dimensional model of lumenogenesis involving CEACAM1. PMID: 28823832
- CEACAM1 also inhibits viral spread in ex vivo human decidua organ culture. PMID: 27264178
- In enterocytic C2BBe1 cells, Candida albicans caused a transient tyrosine phosphorylation of CEACAM1 and induced higher expression of membrane-bound CEACAM1 and soluble CEACAM6. PMID: 28292985
- REVIEW: summarizes the vascular effects of CEACAM1 and focuses on its role in vascular morphogenesis and endothelial barrier regulation PMID: 27695943
- We also found that MMP12 facilitated type I collagen induced platelet aggregation, adhesion and alpha granule secretion. Similarly, one short peptide, WYKG, facilitated type I collagen induced platelet alpha granule secretion. We conclude that platelet express MMP12 may facilitate platelet activation through shedding of CEACAM1. PMID: 28385529
- We demonstrate that recombinant Neisseria Opa proteins reconstituted into liposomes retain the ability to recognize and interact with CEACAM1 and 3 in vitro but do not maintain receptor specificity compared to that of Opa proteins natively expressed by Neisseria gonorrhoeae. PMID: 27442026
- use NMR cross-correlation measurements to examine the effect of glycosylation on CEACAM1-IgV dimerization and use residual dipolar coupling (RDC) measurements to characterize the solution structure of the non-glycosylated form. PMID: 27471271
- miRNA-342 Regulates CEACAM1-induced Lumen Formation in a Three-dimensional Model of Mammary Gland Morphogenesis. PMID: 27302063
- The diffuse and cytoplasmic expression of CD66a may involve the early stage of the hepatocellular carcinoma , and the loss of CD66a expression indicates tumor progression. PMID: 27377843
- this study shows that the expression of CEACAM1 is correlated with advanced stage and could be independent risk factors for colorectal cancer PMID: 28038383
- Increased serum CEA level reflected CEACAM1 expression and was an independent factor predictive of recurrence in hepatocellular carcinoma through epithelial-mesenchymal transition and tumor angiogenesis PMID: 28314278
- CEACAM1 might be regarded as a marker of salivary glandular tumors. PMID: 27464654
- CEACAM1 mediates bacterial adherence and transcellular transcytosis. PMID: 26081722
- CEACAM1 might play an important role in ovarian tumor progression, especially in tumor metastasis PMID: 26653024
- Osteosarcoma patients with higher CEACAM1 had relatively lower survival compared to those with low CEACAM1 and high serum CEACAM1 level was an independent prognostic factor for osteosarcoma PMID: 27074014
- serum CEACAM1 is elevated over time in progressive melanoma patients who fail to respond to immunotherapy as opposed to responders and stable disease patients. PMID: 26688824
- an MITF-CEACAM1 axis is suggested as a potential determinant of melanoma progression. PMID: 26301891
- Collectively, these data suggest that vIL-6 modulates endothelial cell migration by upregulating the expression of cellular factors, including CEACAM1. PMID: 26646010
- Taken together, our results demonstrate a systematic down-regulation of CEACAM1 in breast cancer and suggest that a strategy to restore CEACAM1 expression may be helpful for the treatment of breast cancer. PMID: 26341981
- Elevated carcinoembryonic antigen expression is associated with recurrence for patients after resection for colorectal liver metastases. PMID: 25582745
- Serum concentrations of CEACAM1 may serve as a useful indicator for the presence of breast cancer PMID: 26343926
- High Carcinoembryonic Antigen expression is associated with colon and stomach cancer. PMID: 26107193
- High carcinoembryonic antigen serum levels are associated with Lung Adenocarcinoma. PMID: 25987049
- High levels of serum CEA, CA72-4, CA19-9 and TSGF are associated with Gastric Cancer. PMID: 25987051
- Ceacam1L acts as a crucial factor in glioblastoma-initiating cell maintenance and tumorigenesis by activating c-Src/STAT3 signaling. Monomers of the cytoplasmic domain of Ceacam1L bound to c-Src and STAT3 and induced their phosphorylation. PMID: 26238781
- Abnormal expression of CD66a promotes proliferation and inhibits apoptosis of human leukemic B cells in vitro PMID: 24716460
- In conclusion, CEACAM1-L isoform expression dominance is associated with invasion, metastasis, and recurrence in hepatocellular carcinoma. PMID: 24390710
- our data show that human and bovine CEACAM1 can both inhibit NK-cell cytotoxicity although they differ in their intracellular signaling motifs PMID: 25824372
- CD66 is a potential tumor marker to differentiate lung adenocarcinoma-associated malignant pleural effusion from benign effusions. PMID: 25551300
- CEACAM1 gene silencing inhibited the cell proliferation and promote the apoptosis in human glioma SHG44 cells. PMID: 25575053
顯示更多
收起更多
-
亞細(xì)胞定位:[Isoform 1]: Cell membrane; Single-pass type I membrane protein. Lateral cell membrane. Apical cell membrane. Basal cell membrane. Cell junction. Cell junction, adherens junction.; [Isoform 2]: Secreted.; [Isoform 3]: Secreted.; [Isoform 4]: Secreted.; [Isoform 5]: Cell membrane; Single-pass type I membrane protein.; [Isoform 6]: Cell membrane; Single-pass type I membrane protein.; [Isoform 7]: Cell membrane; Single-pass type I membrane protein.; [Isoform 8]: Cell membrane; Single-pass type I membrane protein. Cytoplasmic vesicle, secretory vesicle membrane. Lateral cell membrane. Apical cell membrane. Basal cell membrane. Cell junction. Cell junction, adherens junction.; Cell projection, microvillus membrane; Single-pass type I membrane protein. Apical cell membrane; Single-pass type I membrane protein.
-
蛋白家族:Immunoglobulin superfamily, CEA family
-
組織特異性:Expressed in columnar epithelial cells of the colon (at protein level). The predominant forms expressed by T cells are those containing a long cytoplasmic domain. Expressed in granulocytes and lymphocytes. Leukocytes only express isoforms 6 and isoform 1.
-
數(shù)據(jù)庫(kù)鏈接:
Most popular with customers
-
-
YWHAB Recombinant Monoclonal Antibody
Applications: ELISA, WB, IHC, IF, FC
Species Reactivity: Human, Mouse, Rat
-
Phospho-YAP1 (S127) Recombinant Monoclonal Antibody
Applications: ELISA, WB, IHC
Species Reactivity: Human
-
-
-
-
-